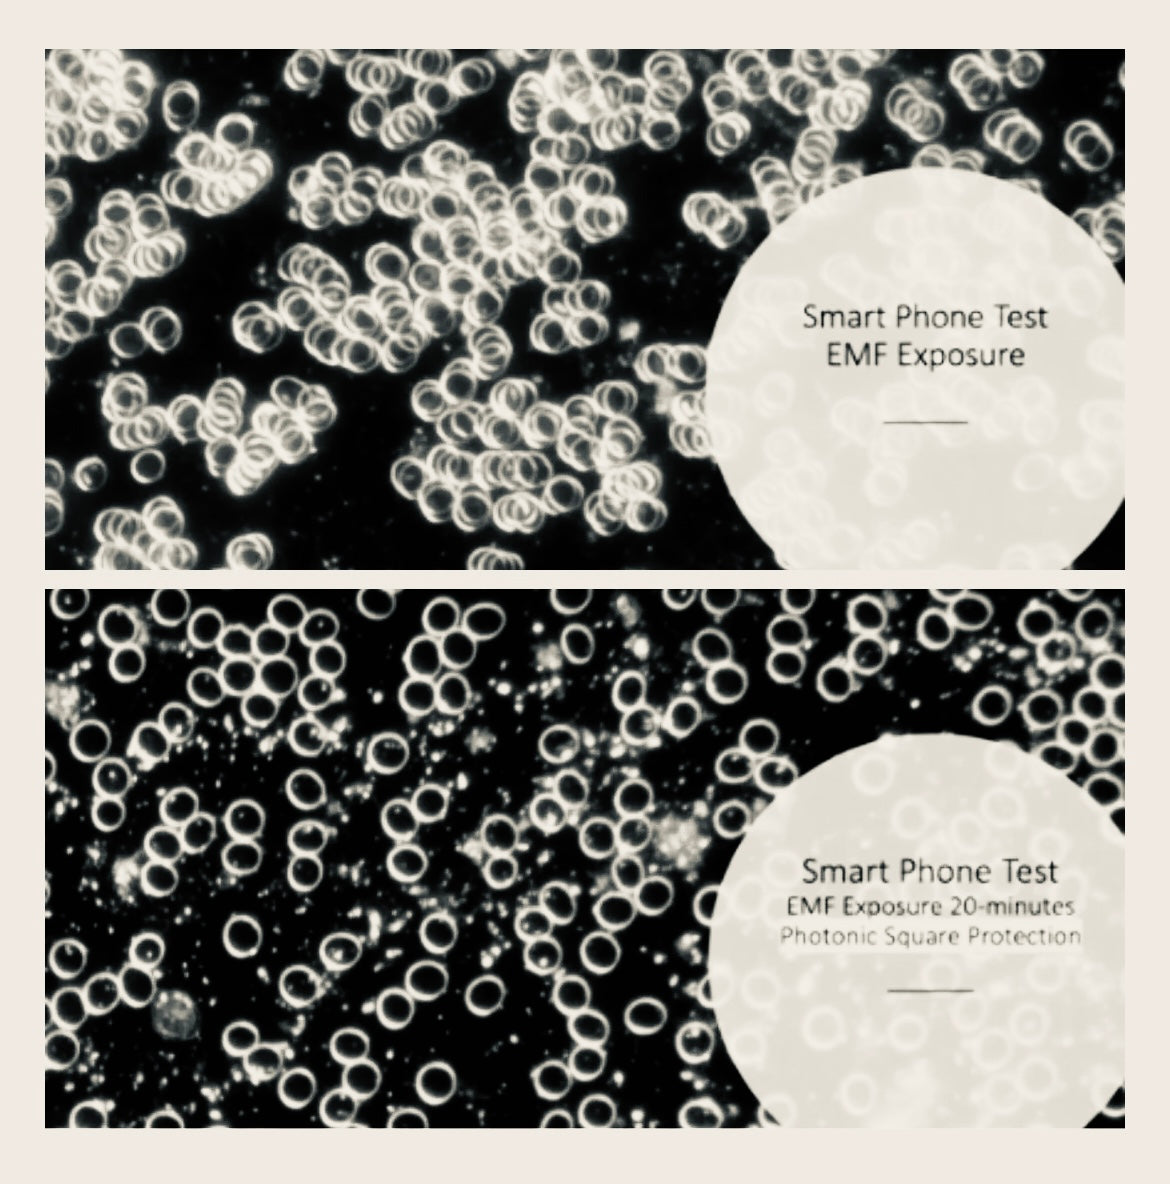

In a time where artificial electromagnetic fields (EMFs) are ever-present, the need to find balance from their possible harmful impacts has grown more important. The Photonic Square and the Shield stand at the forefront of innovative solutions, ingeniously designed to mitigate electromagnetic radiation emitted by an overabundance of wireless devices.
This blog explores the essence of photonic technology, its operational principles and the significant benefits it gives.
At the heart of the Photonic Square is a multi-layered structure, meticulously crafted from select metal alloys and dielectric materials. This configuration transcends conventional barriers, acting as a sophisticated converter of high-frequency electromagnetic fields. By transforming detrimental radiation into frequencies that resonate positively with human health and biological systems, the Photonic Square demonstrates a new paradigm in EMF protection. Its efficacy spans a broad spectrum of devices, including but not limited to, smart meters, mobile phones, Wi-Fi routers, thereby rendering it an essential component in today’s digitally saturated climate.
Similarly, the Photonic Crystal Shield transcends mere EMF shielding to embody wellness enhancement. It actively improves the balance of the body's meridians and enhances water structure quality, harnessing the intricate dynamics between electromagnetic fields and biological systems to mitigate environmental stressors. Whether utilised in personal vehicles or amidst the dynamic flux of daily life, the Photonic Crystal Shield signifies a commitment to a more harmonised state of existence.
Photonic technology is deeply rooted in a comprehensive understanding of electromagnetic fields. It differentiates between the beneficial natural EMFs, inherent to the Earth, and the artificial EMFs emanating from modern electronic appliances, which have been implicated in various health concerns. Photonic devices are designed to transform these artificial EMFs into frequencies that enhance rather than compromise biological integrity.
Research, including insights from Bio initiative highlights the increasing prevalence of artificial EMFs and their association with modern health dilemmas. Photonic technology emerges as a proactive defence against these environmental challenges.
Dedicated to our mission of fostering a healthier, more harmonious living environment, we are thrilled to announce a special promotion: the Photonic Square and Photonic Crystal Shield are now available at half price until this Sunday, 7th April, subject to stock availability. This exceptional offer underscores our commitment to the well-being of our community.
For more information on research and the photonic follow this link - https://atta.life/pages/energy-protect